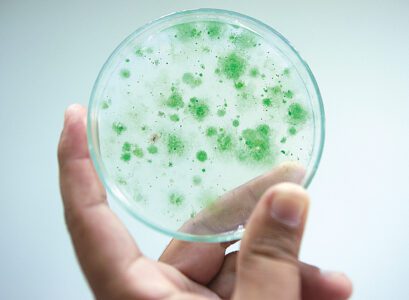
article image -

Donalds introduces Combat Harmful Algal Blooms Act
Congressman Byron Donalds (R-19), whose district includes Fort Myers Beach, most of Lee County and Collier County, reintroduced the Combat Harmful Agal Blooms Act (House Resolution 1008), which allows for the inclusion of algal blooms to the applicability of major disaster declarations.
The office of Donalds stated that the legislation is meant to “preserve vital marine ecosystems.”
The resolution states that harmful algal blooms, depending on the severity, may result in widespread mortality of marine life and aquatic specimens among other impacts.
“Water is Florida’s most important natural resource and serves as the heart and soul of Southwest Florida,” Donalds stated. “I’m committed to advancing bipartisan policies that promote the preservation of our waterways against potential long-term damage resulting from harmful algal blooms. This bill gives state and local leaders the opportunity to request federal funding to protect their waterways for future generations to come. I’m thankful for my colleagues’ support in this effort to protect our nation’s marine ecosystems.”
The resolution states that harmful algal blooms “can force the closure of beaches, impose fishing and shellfish harvesting restrictions, and could even result in banning the sale of seafood at restaurants.”
The resolution states that “tourism numbers can drop dramatically during harmful algal blooms, which may result in a significant economic impact to certain economies that heavily depend on bringing in visitors. Property values near water sources that experience harmful algal blooms may decrease substantially.”
The Florida Department of Environmental Protection has been documenting numerous algal blooms throughout Florida and Southwest Florida which it documents on its website.
To reach NATHAN MAYBERG, please email nmayberg@breezenewspapers

